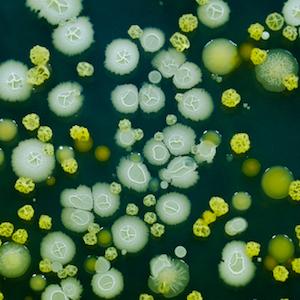

Classifying species is a notoriously sticky problem in biology. As a very broad rule, organisms can be classified as belonging to a distinct species if they can successfully mate with each other to produce offspring that can also successfully mate.
But this rule completely falls apart for microbes. Bacteria reproduce asexually; they simply divide into two "daughter" cells. They also promiscuously swap DNA with other bacterial species, such as antibiotic resistance genes. So, bacteria are classified mostly based upon similarity in DNA sequences.
All of this fuss over bacterial taxonomy may seem to be merely an academic exercise, but understanding differences between the "core genome" and "accessory genes" is important for both medical microbiology as well as synthetic biology. To further this understanding, Prof J. Peter Young suggests in Trends in Microbiology that we ought to think of the bacterial core genome as an operating system and accessory genes as apps.
He makes a solid case. Bacteria of the same species often greatly differ in their characteristics, even though they share the same core genes. Just like one person's iPhone might have mostly news apps and another person's only music apps -- thus, on the surface they seem like completely different devices -- the fact remains that they are both iPhones. Dr Young paints a brilliant analogy:
Phones are shipped from the factories in a limited range of models (species) with standard operating systems (core genes), but users download apps (accessory gene modules) from the internet (community gene pool) so there are soon millions of distinct combinations of software (genotypes). Rather than accessing a central app store, bacteria adapt through peer-to-peer networking (horizontal gene transfer), and the process is generally passive as far as the recipient is concerned. It is more akin to email spam – new genes are constantly arriving in the inbox, despite advanced spam filters and antiviral software (CRISPR and restriction). Bacteria are constantly hitting the ‘delete’ key, but every now and then something really useful turns up and is kept.
Dr Young proposes that thinking of bacteria in this way will allow biologists to properly construct evolutionary histories by analyzing the core genome. The "apps" (e.g., antibiotic resistance), which are encoded by accessory genes, cannot be used for this purpose for the same reason that a person's iPhone apps tell you very little about the iPhone itself: There is too much variation from one individual to the next. Just like an iPhone's apps are tailored to the specific needs of the user, bacteria adapt to their environment by employing various accessory genes.
Thinking of genes in this way opens up new questions. Most importantly for medical microbiology is predicting which apps (accessory genes) are compatible with which operating systems (core genomes). Gaining insights here could help predict the spread of antibiotic resistance.
Source: J. Peter W. Young. "Bacteria Are Smartphones and Mobile Genes Are Apps." Trends Microbiol. In press. DOI: http://dx.doi.org/10.1016/j.tim.2016.09.002